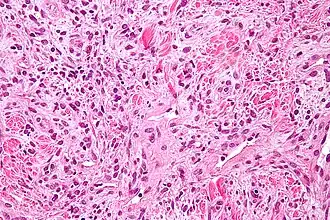

Pericyt





Pericyten (vroeger Rouget-cellen genoemd)[1] zijn multifunctionele cellen van de microcirculatie, die rondom de endotheelcellen van de haarvaten zitten.[2] Ze hebben primaire uitlopers die zich in de lengterichting langs de haarvatwand uitstrekken en secundaire laterale uitlopers die zich rondom het haarvat uitstrekken. Het cytoplasma van pericyten bevat microtubuli die zich langs de as van de primaire uitsteeksels uitstrekken. Ze werden voor het eerst geïdentificeerd in de jaren 1870, maar er werd in de daaropvolgende eeuw weinig aandacht aan besteed.[3] De naam pericyt werd door Zimmerman in 1923 aan de cel gegeven.[4] Pericyten zijn ingebed in het basaalmembraan van haarvaten, waar ze communiceren met endotheelcellen door middel van zowel direct fysiek contact als paracriene celsignalering.[5] De morfologie, distributie, dichtheid en moleculaire vingerafdrukken van pericyten variëren tussen organen en bloedvaten.[6][7] Pericyten helpen bij het handhaven van homeostatische en hemostatische functies in de hersenen, dat een van de organen is die wordt gekenmerkt door een hogere pericytbedekking. Ze ondersteunen ook de bloed-hersenbarrière.[8] Deze cellen zijn ook een belangrijk onderdeel van het neurovasculair systeem, die endotheelcellen, astrocyten en zenuwcellen omvat.[9][10] Er wordt verondersteld dat pericyten de bloedstroom door de haarvaten reguleren.[11][12][13][14] In vitro verwijderden ze celresten door fagocytose.[15] Pericyten stabiliseren en bewaken de rijping van endotheelcellen door middel van directe communicatie tussen het celmembraan en via paracriene signalering.[16] Een tekort aan pericyten in het centraal zenuwstelsel kan leiden tot een verhoogde doorlaatbaarheid van de bloed-hersenbarrière.[8]
Structuur
In het centraalzenuwstelsel omgeven de pericyten de endotheelcellen die de binnenkant van de haarvaten bekleden. Deze twee soorten cellen kunnen gemakkelijk van elkaar worden onderscheiden op basis van de aanwezigheid van de ronde celkern van de pericyt in vergelijking met de platte langwerpige celkern van de endotheelcellen.[9] Pericyten hebben ook vingerachtige uitsteeksels die zich om de haarvatwand wikkelen, waardoor de cellen de bloedstroom in het haarvat kunnen reguleren.[8]
Zowel pericyten als endotheelcellen delen een basaalmembraan waar verschillende intercellulaire verbindingen worden gemaakt. Veel soorten integrinemoleculen vergemakkelijken de communicatie tussen pericyten en endotheelcellen die gescheiden worden door het basaalmembraan.[8] Pericyten kunnen ook directe verbindingen vormen met aangrenzende cellen door het vormen van pen-en-gat-verbingen waarin delen van de cellen in elkaar grijpen, vergelijkbaar met de tandwielen van een klok. Op deze in elkaar grijpende plekken kunnen gap junctions worden gevormd, waardoor de pericyten en aangrenzende cellen ionen en kleine moleculen kunnen uitwisselen.[8] Belangrijke moleculen in deze intercellulaire verbindingen zijn onder andere N-cadherine, fibronectine, connexine en verschillende integrinen.[9]
In sommige regio's van het basaalmembraan kunnen focale adhesies worden gevonden die zijn samengesteld uit fibronectine. Deze focale adhesies vergemakkelijken de verbinding van het basaalmembraan met de cytoskelet die is samengesteld uit actine en het celmembraan van de pericyten en endotheelcellen.[8] Het actine cytoskelet van een cel wordt door de focale adhesie mechanisch gekoppeld aan het substraat (de extracellulaire matrix).
Functie
Skeletspierregeneratie en vetvorming
Pericyten in de dwarsgestreepte skeletspieren zijn twee verschillende populaties, elk met hun eigen rol.[17] Het eerste pericytensubtype (Type-1) kan differentiëren tot vetcellen, terwijl het andere (Type-2) tot spiercellen kan differentiëren. Type-1 wordt gekenmerkt door negatieve expressie voor nestine (PDGFRβ+CD146+Nes-) en type-2 wordt gekenmerkt door positieve expressie voor nestine (PDGFRβ+CD146+Nes+). Hoewel beide typen kunnen prolifereren als reactie op glycerol- of bariumchloride-geïnduceerde verwonding, geven type-1-pericyten alleen aanleiding tot adipocyten als reactie op glycerolinjectie en gaan type-2 skeletspiercellen vormen als reactie op beide typen verwonding.[18][19] Het is niet bekend in welke mate type-1 pericyten bijdragen aan de vetophoping.
Angiogenese en de overleving van endotheelcellen
Pericyten worden ook geassocieerd met endotheelceldifferentiatie en -proliferatie, angiogenese, overleving van apoptotische signalen en celmigratie. Bepaalde pericyten, bekend als microvasculaire pericyten, ontwikkelen zich rond de wanden van haarvaten en helpen deze hun functie te vervullen. Haarvatpericyten zijn mogelijk geen samentrekkende cellen, omdat ze geen alfa-actine-isovormen hebben, structuren die veel voorkomen bij andere samentrekkende cellen. Deze cellen communiceren met endotheelcellen via gap junctions en zorgen er op hun beurt voor dat endotheelcellen prolifereren of selectief worden geremd. Als dit proces niet zou plaatsvinden, zouden hyperplasie en abnormale vasculaire morfogenese het gevolg kunnen zijn. Deze typen pericyten kunnen ook exogene eiwitten fagocyteren. Dit suggereert dat het celtype mogelijk is afgeleid van microglia.[20]
Er is een typeringsrelatie met andere celtypen voorgesteld, waaronder gladde spiercellen,[21] zenuwcellen,[21] NG2 glia,[22] NG2 gliacel,[19] spiervezels, adipocyten, evenals fibroblasten[23] en andere mesenchymatische stamcellen. Het regeneratieve vermogen van pericyten wordt beïnvloed door veroudering.[23] Een dergelijke veelzijdigheid is nuttig, omdat ze actief bloedvaten in het hele lichaam opnieuw bewerken en daardoor homogeen kunnen opgaan in de lokale weefselomgeving.[24]
Naast het creëren en opnieuw bewerken van bloedvaten, is gebleken dat pericyten endotheelcellen beschermen tegen dood door apoptose of cytotoxische elementen. In vivo is aangetoond dat pericyten een hormoon vrijgeven dat bekendstaat als pericytische aminopeptidase N/pAPN, dat kan helpen angiogenese te bevorderen. Toen dit hormoon werd gemengd met endotheelcellen in de grote hersenen en astrocyten, groepeerden de pericyten zich in structuren die leken op haarvaten. Bovendien, wanneer de experimentele groep geen pericyten bevatten, zouden de endotheelcellen apoptose ondergaan. Er werd dus geconcludeerd dat pericyten aanwezig moeten zijn om de juiste functie van endotheelcellen te garanderen, en astrocyten moeten aanwezig zijn om ervoor te zorgen dat beide in contact blijven. Als dat niet het geval is, kan er geen goede angiogenese plaatsvinden.[25] Er is ook ontdekt dat pericyten bijdragen aan het overleven van endotheelcellen, omdat ze het eiwit Bcl-w afscheiden tijdens cellulaire over en weer beïnvloeding. Bcl-w is een instrumenteel eiwit in het pad dat VEGF-A-expressie afdwingt en apoptose ontmoedigt.[26] Hoewel er enige speculatie is over de reden waarom VEGF direct verantwoordelijk is voor het voorkomen van apoptose, wordt aangenomen dat het verantwoordelijk is voor het moduleren van apoptotische signaaltransductiepaden en het remmen van de activering van apoptose-inducerende enzymen. Twee biochemische mechanismen die door VEGF worden gebruikt om dit te bereiken, zijn fosforylering van extracellulaire regulerende kinase 1 (ERK-1), die de overleving van cellen in de loop van de tijd in stand houdt, en remming van stress-geactiveerde proteïnekinase/c-jun-NH2-kinase, die ook apoptose bevordert.[27]
Bloed-hersenbarrière
Pericyten spelen een cruciale rol in de vorming en functionaliteit van de bloed-hersenbarrière. Deze barrière bestaat uit endotheelcellen en zorgt voor de bescherming en functionaliteit van de hersenen en het centraal zenuwstelsel. Er is ontdekt dat pericyten na de geboorte cruciaal zijn voor de vorming van deze barrière. Pericyten zijn verantwoordelijk voor de vorming van zonula occludens en vesikeltransport tussen endotheelcellen. Bovendien maken ze de vorming van de bloed-hersenbarrière mogelijk door de effecten van de centraal zenuwstelsel-witte bloedcellen (die de vorming van de barrière kunnen beschadigen) te remmen en door de expressie van moleculen die de vasculaire doorlaatbaarheid verhogen, te verminderen.[28]
Naast de vorming van de bloed-hersenbarrière spelen pericyten ook een actieve rol in de functionaliteit ervan. Diermodellen met ontwikkelingsverlies van pericyten tonen verhoogde endotheeltranscytose, evenals arterioveneuze malformatie, verhoogde expressie van leukocytadhesiemoleculen en microaneurysma's.[29][30] Er wordt ook verondersteld dat het verlies of de disfunctie van pericyten bijdraagt aan neurodegeneratieve ziekten zoals de ziekte van Alzheimer,[31][32][33] de ziekte van Parkinson en ALS[34] door het afbreken van de bloed-hersenbarrière.
Bloedstroom
Steeds meer bewijs suggereert dat pericyten de bloedstroom op haarvatniveau kunnen reguleren. Voor het netvlies zijn er films gepubliceerd[14] die laten zien dat pericyten haarvaten vernauwen wanneer hun membraanpotentiaal wordt gewijzigd om calciuminstroom op gang te brengen, en in de hersenen is gerapporteerd dat neuronale activiteit de lokale bloedstroom verhoogt door pericyten aan te zetten haarvaten te verwijden voordat stroomopwaartse arteriole verwijding optreedt.[13] Het lijkt erop dat verschillende signaalpaden de vernauwing van haarvaten door pericyten en van arteriolen door gladde spiercellen reguleren.[35] Studies bij ratten hebben een dergelijk signaalpad gevonden waarin na een verwonding aan het ruggenmerg en geïnduceerde hypoxie onder de verwonding, er sprake is van overmatige activiteit van monoaminereceptoren op pericyten die lokaal haarvaten vernauwen en de bloedstroom tot ischemische niveaus reduceren.[36]
Pericyten zijn belangrijk bij het in stand houden van de bloedsomloop. In een studie met volwassen muizen met pericyte-deficiëntie werd de cerebrale bloedstroom verminderd met gelijktijdige vasculaire regressie als gevolg van verlies van zowel endotheel als pericyten. Er werd significant grotere hypoxie gerapporteerd in de hippocampus van muizen met pericyte-deficiëntie, evenals ontsteking, en leer- en geheugenstoornissen.[37]
Interstitiële druk
De interstitiële druk waaraan pericyten worden blootgesteld, zal naar verwachting voor elk subtype verschillen vanwege de verschillen in lokalisatie; de druk wordt geschat op ongeveer 50 mmHg voor ePC's, ongeveer 30 mmHg voor tsPC's en ongeveer 15 mmHg voor sPC's. ePC's zijn pericyten rondom pre-haarvaten, tsPC's zijn dunstrengige pericyten op haarvaten en sPC's zijn stervormige pericyten op post-haarvaten.[38]
Klinische betekenis
Vanwege hun cruciale rol bij het handhaven en reguleren van de structuur van endotheelcellen en de bloedstroom, worden afwijkingen in de pericytfunctie gezien bij veel pathologieën. Ze kunnen ofwel in overmaat aanwezig zijn, wat leidt tot ziekten zoals hypertensie en tumorvorming, of in deficiëntie, wat leidt tot neurodegeneratieve ziekten, zoals de ziekte van Alzheimer, de ziekte van Parkinson en ALS.
Hemangioom
De klinische fasen van hemangioom hebben fysiologische verschillen, gecorreleerd met door Takahashi et al. opgestelde immunofenotypische profielen. Tijdens de vroege proliferatieve fase (0-12 maanden) brengen de tumoren prolifererend celkernantigeen (pericytesna), vasculair endotheliale groeifactor (VEGF) en type IV collageenase (MMP2) tot expressie, de eerste twee gelokaliseerd in zowel endotheel als pericyten, en de laatste alleen in endotheel. De vasculaire merkers CD31, Vonwillebrandfactor (vWF) en gladde spieractine (pericytmerker) zijn aanwezig tijdens de prolifererende en involutieve fase, maar gaan verloren nadat de laesie volledig is geïnvolueerd.[39]
Hemangiopericytoom
Hemangiopericytoom is een zeldzame vasculaire neoplasie, of abnormale groei, die goedaardig of kwaadaardig kan zijn. In zijn kwaadaardige vorm kan er uitzaaiing optreden naar de longen, lever, hersenen en armen en benen. Het manifesteert zich meestal in het dijbeen en proximale scheenbeen als een osteosarcoom, en wordt meestal aangetroffen bij oudere personen, hoewel er gevallen zijn gevonden bij kinderen. Hemangiopericytoom wordt veroorzaakt door de overmatige lagen pericyten rond onjuist gevormde bloedvaten. De diagnose van deze tumor is moeilijk vanwege het onvermogen om pericyten te onderscheiden van andere soorten cellen met behulp van lichtmicroscopie. De behandeling kan chirurgische verwijdering en radiotherapie omvatten, afhankelijk van de mate van botpenetratie en het stadium in de ontwikkeling van de tumor.[40]
Diabetische retinopathie

Het netvlies van diabetische personen vertoont vaak verlies van pericyten, en dit verlies is een kenmerkende factor van de vroege stadia van diabetische retinopathie. Studies hebben aangetoond dat pericyten essentieel zijn bij diabetische personen om de endotheelcellen van netvlies haarvaten te beschermen. Bij het verlies van pericyten vormen zich microaneurysma's in de haarvaten. Als reactie hierop verhoogt het netvlies ofwel zijn vasculaire doorlaatbaarheid, wat leidt tot zwelling van het oog door een macula-oedeem, of vormt het nieuwe vaten die doordringen in het glasvocht van het oog. Het eindresultaat is vermindering of verlies van het gezichtsvermogen.[41] Hoewel het onduidelijk is waarom pericyten verloren gaan bij diabetische patiënten, is een hypothese dat toxische sorbitol en glycosyleringseindproducten (AGE) zich ophopen in de pericyten. Vanwege de opbouw van glucose verhoogt het polyolpad zijn doorstroom, en hopen intracellulaire sorbitol en fructose zich op. Dit leidt tot osmotische onbalans, wat resulteert in celschade. De aanwezigheid van hoge glucosespiegels leidt ook tot de opbouw van AGE's, die ook cellen beschadigen.[42]
Neurodegeneratieve ziekten
Uit onderzoek is gebleken dat verlies van pericyten in de volwassen en ouder wordende hersenen leidt tot verstoring van de juiste hersendoorbloeding en het behoud van de bloed-hersenbarrière, wat neurodegeneratie en zenuwontsteking veroorzaakt. De apoptose van pericyten in de ouder wordende hersenen kan het gevolg zijn van een storing in de communicatie tussen groeifactoren en receptoren op pericyten. Platelet-derived growth factor B (PDGFB) wordt vrijgegeven door endotheelcellen in het hersenvaatstelsel en bindt zich aan de receptor PDGFRB op pericyten, waardoor hun proliferatie en bijdrage aan het vaatstelsel wordt geïnitieerd.

Immuunhistochemische onderzoeken van menselijk weefsel van de ziekte van Alzheimer en amyotrofische laterale sclerose tonen verlies van pericyten en afbraak van de bloed-hersenbarrière. Muismodellen met een tekort aan pericyten (die genen missen die coderen voor stappen in de PDGFB:PDGFRB-signaalcascade) en een mutatie hebben die Alzheimer veroorzaakt, hebben een Alzheimer-achtige pathologie die verergerd is vergeleken met muizen met een normale pericytenbedekking en een mutatie die Alzheimer veroorzaakt.
Beroerte
Bij een beroerte vernauwen pericyten de haarvaten in de hersenen en sterven vervolgens af, wat kan leiden tot een langdurige afname van de bloedstroom en verlies van de bloed-hersenbarrièrefunctie, waardoor de dood van zenuwcellen toeneemt.[13]
Endotheel- en pericytinteracties
Endotheelcellen en pericyten zijn onderling afhankelijk en het uitblijven van een goede communicatie tussen de twee celtypen kan leiden tot talrijke menselijke pathologieën.[43]
Er zijn verschillende communicatiepaden tussen de endotheelcellen en pericyten. De eerste is de signalering van de transformerende groeifactor (TGF), die wordt gemedieerd door endotheelcellen. Dit is belangrijk voor de differentiatie van pericyten.[44][45] Angiopoietine 1 en Tie-2-signalering zijn essentieel voor de rijping en stabilisatie van endotheelcellen.[46] De signalering van de plaatjesafgeleide groeifactor (PDGF)-route van endotheelcellen rekruteert pericyten, zodat pericyten kunnen migreren naar zich ontwikkelende bloedvaten. Als dit pad wordt geblokkeerd, leidt dit tot een tekort aan pericyten.[47] Sfingosine-1-fosfaat (S1P)-signalering helpt ook bij de rekrutering van pericyten door communicatie via G-proteïnegekoppelde receptoren. S1P stuurt signalen via GTPases die N-cadherinetransport naar endotheelmembranen bevorderen. Dit transport versterkt endotheelcontacten met pericyten.[48]
Communicatie tussen endotheelcellen en pericyten is van vitaal belang. Het remmen van het PDGF-pad leidt tot pericytdeficiëntie. Dit veroorzaakt endotheelhyperplasie, abnormale verbindingen en diabetische retinopathie.[41] Een gebrek aan pericyten veroorzaakt ook een upregulatie van vasculair endotheliale groeifactor (VEGF), wat leidt tot vaatlekkage en bloeding.[49] Angiopoietine 2 kan fungeren als een antagonist voor Tie-2,[50] waardoor de endotheelcellen worden gedestabiliseerd, wat resulteert in minder interactie tussen endotheelcellen en pericyten. Dit leidt af en toe tot de vorming van tumoren.[51] Net als de remming van het PDGF-pad verlaagt angiopoietine 2 de niveaus van pericyten, wat leidt tot diabetische retinopathie.[52]
Bijdrage van pericyten aan de neurogenese bij volwassenen
Het nieuwe bewijsmateriaal (vanaf 2019) suggereert dat neurale arteriole pericyten, onder instructie van aanwezige gliacellen, worden geherprogrammeerd tot interneuronen en lokale neuronale microcircuits verrijken.[53]Deze respons wordt versterkt door gelijktijdige angiogenese.
- voetnoten
- ↑ Dore-Duffy, P. (2008). Pericytes: Pluripotent cells of the blood brain barrier. Current Pharmaceutical Design 14 (16): 1581–93. PMID 18673199. DOI: 10.2174/138161208784705469.
- ↑ Birbrair A, Zhang T, Wang ZM, Messi ML, Mintz A, Delbono O (January 2015). Pericytes at the intersection between tissue regeneration and pathology. Clinical Science 128 (2): 81–93. PMID 25236972. PMC 4200531. DOI: 10.1042/CS20140278.
- ↑ Brown LS, Foster CG, Courtney J-M, King NE, Howells DW and Sutherland BA (2019) Pericytes and Neurovascular Function in the Healthy and Diseased Brain. Front. Cell. Neurosci. 13:282. doi: 10.3389/fncel.2019.00282
- ↑ Zimmermann, K. W. (1923). Der Feinere Bau der Blutcapillaren. Z. Anat. Entwicklungsgesch. 68, 29-109.
- ↑ Bergers G, Song S (October 2005). The role of pericytes in blood-vessel formation and maintenance. Neuro-Oncology 7 (4): 452–64. PMID 16212810. PMC 1871727. DOI: 10.1215/S1152851705000232.
- ↑ (en) Sims, David E. (January 1986). The pericyte—A review. Tissue and Cell 18 (2): 153–174. PMID 3085281. DOI: 10.1016/0040-8166(86)90026-1.
- ↑ (en) Muhl, Lars, Genové, Guillem, Leptidis, Stefanos, Liu, Jianping, He, Liqun (December 2020). Single-cell analysis uncovers fibroblast heterogeneity and criteria for fibroblast and mural cell identification and discrimination. Nature Communications 11 (1): 3953. ISSN: 2041-1723. PMID 32769974. PMC 7414220. DOI: 10.1038/s41467-020-17740-1.
- ↑ a b c d e f Winkler EA, Bell RD, Zlokovic BV (October 2011). Central nervous system pericytes in health and disease. Nature Neuroscience 14 (11): 1398–1405. PMID 22030551. PMC 4020628. DOI: 10.1038/nn.2946.
- ↑ a b c Dore-Duffy P, Cleary K (2011). The Blood-Brain and Other Neural Barriers. DOI:10.1007/978-1-60761-938-3_2, "Morphology and properties of pericytes", 49–68. ISBN 978-1-60761-937-6.
- ↑ Liebner S, Czupalla CJ, Wolburg H (2011). Current concepts of blood-brain barrier development. The International Journal of Developmental Biology 55 (4–5): 467–76. PMID 21769778. DOI: 10.1387/ijdb.103224sl.
- ↑ (en) Hartmann, David A., Berthiaume, Andrée-Anne, Grant, Roger I., Harrill, Sarah A., Koski, Tegan (May 2021). Brain capillary pericytes exert a substantial but slow influence on blood flow. Nature Neuroscience 24 (5): 633–645. ISSN: 1097-6256. PMID 33603231. PMC 8102366. DOI: 10.1038/s41593-020-00793-2.
- ↑ Hill RA, Tong L, Yuan P, Murikinati S, Gupta S, Grutzendler J (July 2015). Regional Blood Flow in the Normal and Ischemic Brain Is Controlled by Arteriolar Smooth Muscle Cell Contractility and Not by Capillary Pericytes. Neuron 87 (1): 95–110. PMID 26119027. PMC 4487786. DOI: 10.1016/j.neuron.2015.06.001.
- ↑ a b c Hall CN, Reynell C, Gesslein B, Hamilton NB, Mishra A, Sutherland BA, O'Farrell FM, Buchan AM, Lauritzen M, Attwell D (April 2014). Capillary pericytes regulate cerebral blood flow in health and disease. Nature 508 (7494): 55–60. PMID 24670647. PMC 3976267. DOI: 10.1038/nature13165.
- ↑ a b Peppiatt CM, Howarth C, Mobbs P, Attwell D (October 2006). Bidirectional control of CNS capillary diameter by pericytes. Nature 443 (7112): 700–4. PMID 17036005. PMC 1761848. DOI: 10.1038/nature05193.
- ↑ (en) Rustenhoven, Justin, Smyth, Leon C., Jansson, Deidre, Schweder, Patrick, Aalderink, Miranda (December 2018). Modelling physiological and pathological conditions to study pericyte biology in brain function and dysfunction. BMC Neuroscience 19 (1): 6. ISSN: 1471-2202. PMID 29471788. PMC 5824614. DOI: 10.1186/s12868-018-0405-4.
- ↑ Fakhrejahani E, Toi M (2012). Tumor angiogenesis: pericytes and maturation are not to be ignored. Journal of Oncology 2012: 1–10. PMID 22007214. PMC 3191787. DOI: 10.1155/2012/261750.
- ↑ Alexander Birbrair, Tan Zhang, Zhong-Min Wang, Maria Laura Messi, Grigori N Enikolopov, Akiva Mintz, Osvaldo Delbono Skeletal Muscle Pericyte Subtypes Differ in their Differentiation Potential Stem Cell Res. 2012 Sep 29;10(1):67–84. doi: 10.1016/j.scr.2012.09.003
- ↑ Alexander Birbrair, Tan Zhang, Zhong-Min Wang, Maria Laura Messi, Grigori N Enikolopov, Akiva Mintz, Osvaldo Delbono Role of Pericytes in Skeletal Muscle Regeneration and Fat Accumulation, Stem Cells Dev. 2013 Mar 21;22(16):2298–2314. doi: 10.1089/scd.2012.0647
- ↑ (en) Birbrair, Alexander, Zhang, Tan, Wang, Zhong-Min, Messi, Maria Laura, Enikolopov, Grigori N. (15 augustus 2013). Role of pericytes in skeletal muscle regeneration and fat accumulation. Stem Cells and Development 22 (16): 2298–2314. ISSN:1557-8534. PMID: 23517218. PMC: 3730538. DOI:10.1089/scd.2012.0647.
- ↑ Pericyte, Astrocyte and Basal Lamina Association with the Blood Brain Barrier (BBB). University of Arizona Health Sciences. Gearchiveerd op 16 February 2017.
- ↑ a b Birbrair A, Zhang T, Wang ZM, Messi ML, Enikolopov GN, Mintz A, Delbono O (January 2013). Skeletal muscle pericyte subtypes differ in their differentiation potential. Stem Cell Research 10 (1): 67–84. PMID 23128780. PMC 3781014. DOI: 10.1016/j.scr.2012.09.003.
- ↑ Birbrair A, Zhang T, Wang ZM, Messi ML, Enikolopov GN, Mintz A, Delbono O (January 2013). Skeletal muscle neural progenitor cells exhibit properties of NG2-glia. Experimental Cell Research 319 (1): 45–63. PMID 22999866. PMC 3597239. DOI: 10.1016/j.yexcr.2012.09.008.
- ↑ a b Birbrair A, Zhang T, Wang ZM, Messi ML, Mintz A, Delbono O (December 2013). Type-1 pericytes participate in fibrous tissue deposition in aged skeletal muscle. American Journal of Physiology. Cell Physiology 305 (11): C1098–113. PMID 24067916. PMC 3882385. DOI: 10.1152/ajpcell.00171.2013.
- ↑ Gerhardt H, Betsholtz C (October 2003). Endothelial-pericyte interactions in angiogenesis. Cell and Tissue Research 314 (1): 15–23. PMID 12883993. DOI: 10.1007/s00441-003-0745-x.
- ↑ Ramsauer M, Krause D, Dermietzel R (August 2002). Angiogenesis of the blood-brain barrier in vitro and the function of cerebral pericytes. FASEB Journal 16 (10): 1274–6. PMID 12153997. DOI: 10.1096/fj.01-0814fje.
- ↑ Franco M, Roswall P, Cortez E, Hanahan D, Pietras K (September 2011). Pericytes promote endothelial cell survival through induction of autocrine VEGF-A signaling and Bcl-w expression. Blood 118 (10): 2906–17. PMID 21778339. PMC 3172806. DOI: 10.1182/blood-2011-01-331694.
- ↑ Gupta K, Kshirsagar S, Li W, Gui L, Ramakrishnan S, Gupta P, Law PY, Hebbel RP (March 1999). VEGF prevents apoptosis of human microvascular endothelial cells via opposing effects on MAPK/ERK and SAPK/JNK signaling. Experimental Cell Research 247 (2): 495–504. PMID 10066377. DOI: 10.1006/excr.1998.4359.
- ↑ Daneman R, Zhou L, Kebede AA, Barres BA (November 2010). Pericytes are required for blood-brain barrier integrity during embryogenesis. Nature 468 (7323): 562–6. PMID 20944625. PMC 3241506. DOI: 10.1038/nature09513.
- ↑ Armulik A, Genové G, Mäe M, Nisancioglu MH, Wallgard E, Niaudet C, He L, Norlin J, Lindblom P, Strittmatter K, Johansson BR, Betsholtz C (November 2010). Pericytes regulate the blood-brain barrier. Nature 468 (7323): 557–61. PMID 20944627. DOI: 10.1038/nature09522.
- Key to blood-brain barrier opens way for treating Alzheimer's and stroke. Karolinska Institutet (October 14, 2010). Gearchiveerd op 1 februari 2014.
- ↑ (en) Mäe, Maarja A., He, Liqun, Nordling, Sofia, Vazquez-Liebanas, Elisa, Nahar, Khayrun (19 februari 2021). Single-Cell Analysis of Blood-Brain Barrier Response to Pericyte Loss. Circulation Research 128 (4): e46–e62. ISSN: 0009-7330. PMID 33375813. PMC 10858745. DOI: 10.1161/CIRCRESAHA.120.317473.
- ↑ (en) Halliday, Matthew R, Rege, Sanket V, Ma, Qingyi, Zhao, Zhen, Miller, Carol A (January 2016). Accelerated pericyte degeneration and blood–brain barrier breakdown in apolipoprotein E4 carriers with Alzheimer's disease. Journal of Cerebral Blood Flow & Metabolism 36 (1): 216–227. ISSN: 0271-678X. PMID 25757756. PMC 4758554. DOI: 10.1038/jcbfm.2015.44.
- ↑ (en) Miners, J Scott, Schulz, Isabel, Love, Seth (January 2018). Differing associations between Aβ accumulation, hypoperfusion, blood–brain barrier dysfunction and loss of PDGFRB pericyte marker in the precuneus and parietal white matter in Alzheimer's disease. Journal of Cerebral Blood Flow & Metabolism 38 (1): 103–115. ISSN: 0271-678X. PMID 28151041. PMC 5757436. DOI: 10.1177/0271678X17690761.
- ↑ (en) Sengillo, Jesse D., Winkler, Ethan A., Walker, Corey T., Sullivan, John S., Johnson, Mahlon (May 2013). Deficiency in Mural Vascular Cells Coincides with Blood-Brain Barrier Disruption in Alzheimer's Disease: Pericytes in Alzheimer's Disease. Brain Pathology 23 (3): 303–310. PMID 23126372. PMC 3628957. DOI: 10.1111/bpa.12004.
- ↑ (en) Winkler, Ethan A., Sengillo, Jesse D., Sullivan, John S., Henkel, Jenny S., Appel, Stanley H. (January 2013). Blood–spinal cord barrier breakdown and pericyte reductions in amyotrophic lateral sclerosis. Acta Neuropathologica 125 (1): 111–120. ISSN: 0001-6322. PMID 22941226. PMC 3535352. DOI: 10.1007/s00401-012-1039-8.
- ↑ Mishra A, Reynolds JP, Chen Y, Gourine AV, Rusakov DA, Attwell D (December 2016). Astrocytes mediate neurovascular signaling to capillary pericytes but not to arterioles. Nature Neuroscience 19 (12): 1619–1627. PMID 27775719. PMC 5131849. DOI: 10.1038/nn.4428.
- ↑ (en) Li, Yaqing, Lucas-Osma, Ana M., Black, Sophie, Bandet, Mischa V., Stephens, Marilee J. (June 2017). Pericytes impair capillary blood flow and motor function after chronic spinal cord injury. Nature Medicine 23 (6): 733–741. ISSN: 1546-170X. PMID 28459438. PMC 5716958. DOI: 10.1038/nm.4331.
- ↑ Bell RD, Winkler EA, Sagare AP, Singh I, LaRue B, Deane R, Zlokovic BV (November 2010). Pericytes control key neurovascular functions and neuronal phenotype in the adult brain and during brain aging. Neuron 68 (3): 409–27. PMID 21040844. PMC 3056408. DOI: 10.1016/j.neuron.2010.09.043.
- ↑ Parazynski, S. E., Tucker, B. J., Aratow, M., Crenshaw, A. and Hargens, A. R. (1993). Direct measurement of capillary blood pressure in the human lip. J. Appl. Physiol.74, 946-950.
- ↑ Prashant Balasaheb Munde, Pericytes in Health and Disease, 22 November 2014, International Journal of Oral and Maxillofacial Pathology 5(1):02-07
- ↑ Gellman, Harris, Solitary Fibrous Tumor. Medscape. Geraadpleegd op 2 november 2011.
- ↑ a b (October 2002). Pericytes and the pathogenesis of diabetic retinopathy. Diabetes 51 (10): 3107–12. PMID 12351455. DOI: 10.2337/diabetes.51.10.3107.
- ↑ (September 2003). Diabetic retinopathy and diabetic macular edema: pathophysiology, screening, and novel therapies. Diabetes Care 26 (9): 2653–64. PMID 12941734. DOI: 10.2337/diacare.26.9.2653.
- ↑ Armulik A, Abramsson A, Betsholtz C (September 2005). Endothelial/pericyte interactions. Circulation Research 97 (6): 512–23. PMID 16166562. DOI: 10.1161/01.RES.0000182903.16652.d7.
- ↑ Carvalho RL, Jonker L, Goumans MJ, Larsson J, Bouwman P, Karlsson S, Dijke PT, Arthur HM, Mummery CL (December 2004). Defective paracrine signalling by TGFbeta in yolk sac vasculature of endoglin mutant mice: a paradigm for hereditary haemorrhagic telangiectasia. Development 131 (24): 6237–47. PMID 15548578. DOI: 10.1242/dev.01529.
- ↑ Hirschi KK, Rohovsky SA, D'Amore PA (May 1998). PDGF, TGF-beta, and heterotypic cell-cell interactions mediate endothelial cell-induced recruitment of 10T1/2 cells and their differentiation to a smooth muscle fate. The Journal of Cell Biology 141 (3): 805–14. PMID 9566978. PMC 2132737. DOI: 10.1083/jcb.141.3.805.
- ↑ Thurston G, Suri C, Smith K, McClain J, Sato TN, Yancopoulos GD, McDonald DM (December 1999). Leakage-resistant blood vessels in mice transgenically overexpressing angiopoietin-1. Science 286 (5449): 2511–4. PMID 10617467. DOI: 10.1126/science.286.5449.2511.
- ↑ Bjarnegård M, Enge M, Norlin J, Gustafsdottir S, Fredriksson S, Abramsson A, Takemoto M, Gustafsson E, Fässler R, Betsholtz C (April 2004). Endothelium-specific ablation of PDGFB leads to pericyte loss and glomerular, cardiac and placental abnormalities. Development 131 (8): 1847–57. PMID 15084468. DOI: 10.1242/dev.01080.
- ↑ Paik JH, Skoura A, Chae SS, Cowan AE, Han DK, Proia RL, Hla T (October 2004). Sphingosine 1-phosphate receptor regulation of N-cadherin mediates vascular stabilization. Genes & Development 18 (19): 2392–403. PMID 15371328. PMC 522989. DOI: 10.1101/gad.1227804.
- ↑ Hellström M, Gerhardt H, Kalén M, Li X, Eriksson U, Wolburg H, Betsholtz C (April 2001). Lack of pericytes leads to endothelial hyperplasia and abnormal vascular morphogenesis. The Journal of Cell Biology 153 (3): 543–53. PMID 11331305. PMC 2190573. DOI: 10.1083/jcb.153.3.543.
- ↑ Maisonpierre PC, Suri C, Jones PF, Bartunkova S, Wiegand SJ, Radziejewski C, Compton D, McClain J, Aldrich TH, Papadopoulos N, Daly TJ, Davis S, Sato TN, Yancopoulos GD (July 1997). Angiopoietin-2, a natural antagonist for Tie2 that disrupts in vivo angiogenesis. Science 277 (5322): 55–60. PMID 9204896. DOI: 10.1126/science.277.5322.55.
- ↑ Zhang L, Yang N, Park JW, Katsaros D, Fracchioli S, Cao G, O'Brien-Jenkins A, Randall TC, Rubin SC, Coukos G (June 2003). Tumor-derived vascular endothelial growth factor up-regulates angiopoietin-2 in host endothelium and destabilizes host vasculature, supporting angiogenesis in ovarian cancer. Cancer Research 63 (12): 3403–12. PMID 12810677.
- ↑ Hammes HP, Lin J, Wagner P, Feng Y, Vom Hagen F, Krzizok T, Renner O, Breier G, Brownlee M, Deutsch U (April 2004). Angiopoietin-2 causes pericyte dropout in the normal retina: evidence for involvement in diabetic retinopathy. Diabetes 53 (4): 1104–10. PMID 15047628. DOI: 10.2337/diabetes.53.4.1104.
- ↑ (en) Farahani, Ramin M., Rezaei-Lotfi, Saba, Simonian, Mary, Xaymardan, Munira, Hunter, Neil (2019). Neural microvascular pericytes contribute to human adult neurogenesis. Journal of Comparative Neurology 527 (4): 780–796. ISSN: 1096-9861. PMID 30471080. DOI: 10.1002/cne.24565.
- bronvermelding
- Dit artikel of een eerdere versie ervan is een (gedeeltelijke) vertaling van het artikel Pericyte op de Engelstalige Wikipedia, dat onder de licentie Creative Commons Naamsvermelding/Gelijk delen valt. Zie de bewerkingsgeschiedenis aldaar.